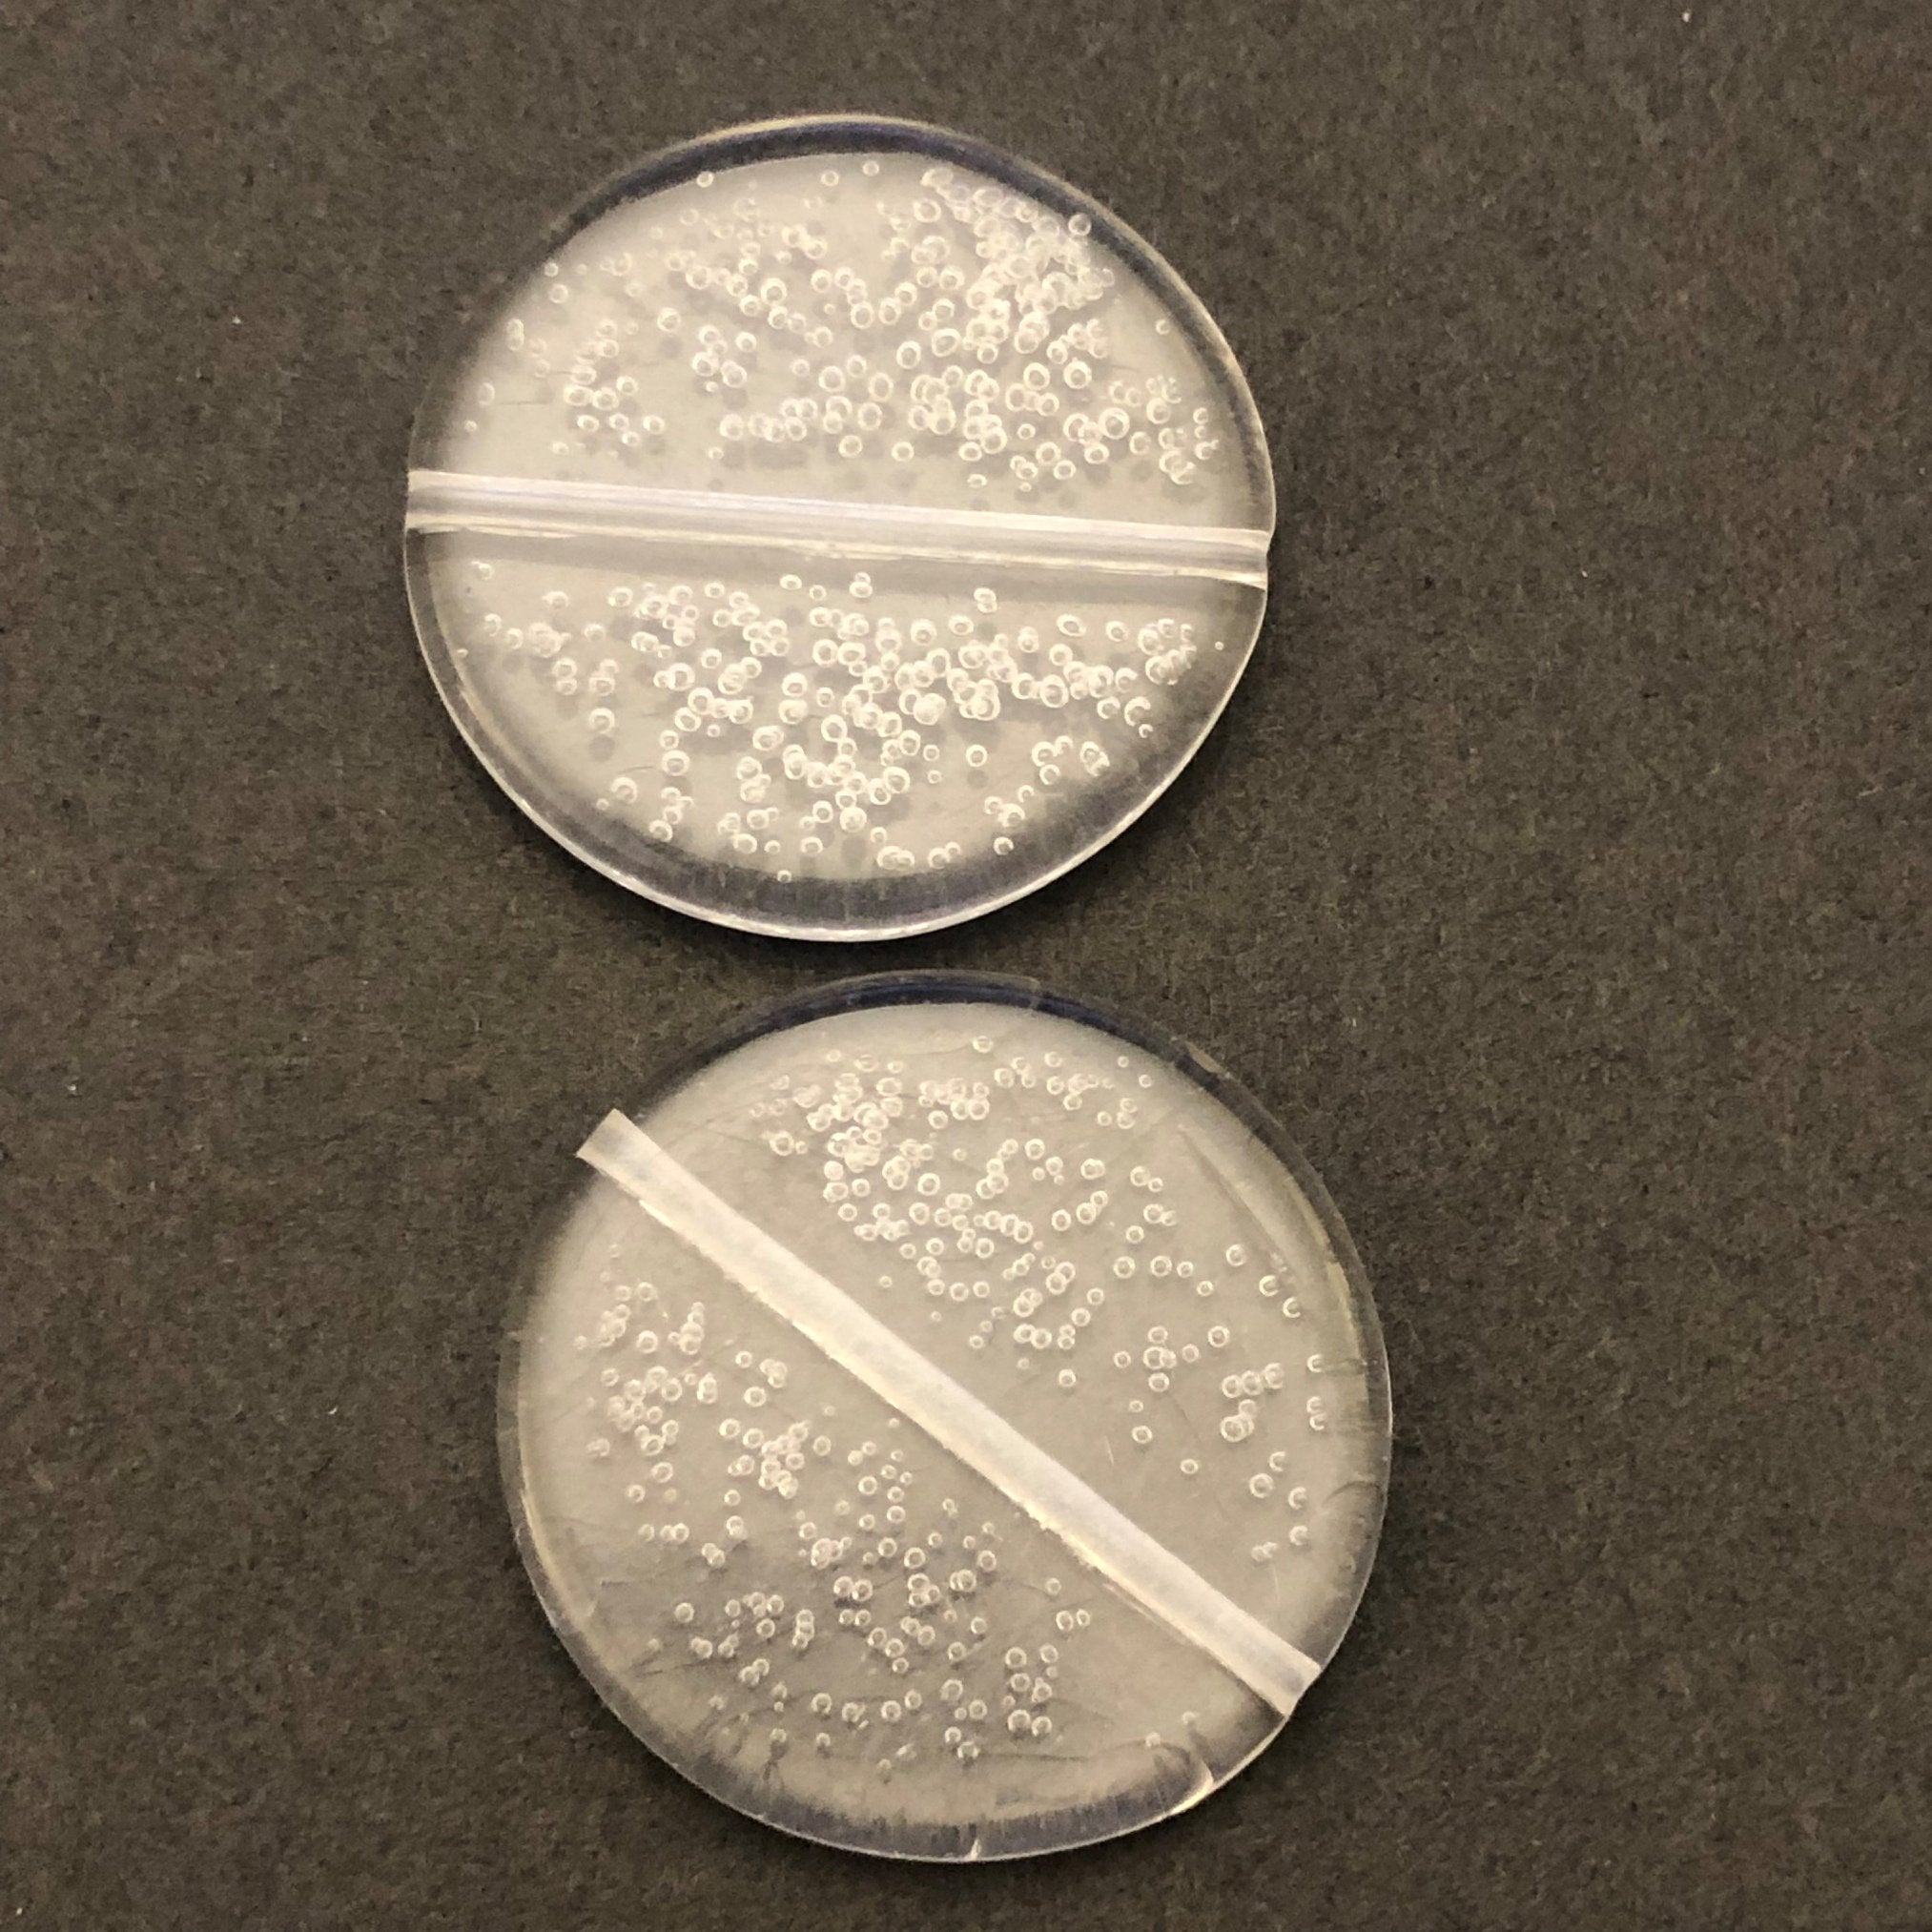
30MM Crystal"Bubbles"Disc Bead (12 pieces)

30MM Crystal"Bubbles"Disc Bead (12 pieces)
These flat transparent crystal acrylic disc beads have through holes from top to bottom, and measure 5mm thick by 30mm in diameter. Inside the beads are tiny scattered floating bubbles, much like a bottle of champagne. The pattern varies from bead to bead. Made in Hong Kong.
Style Number: H1201